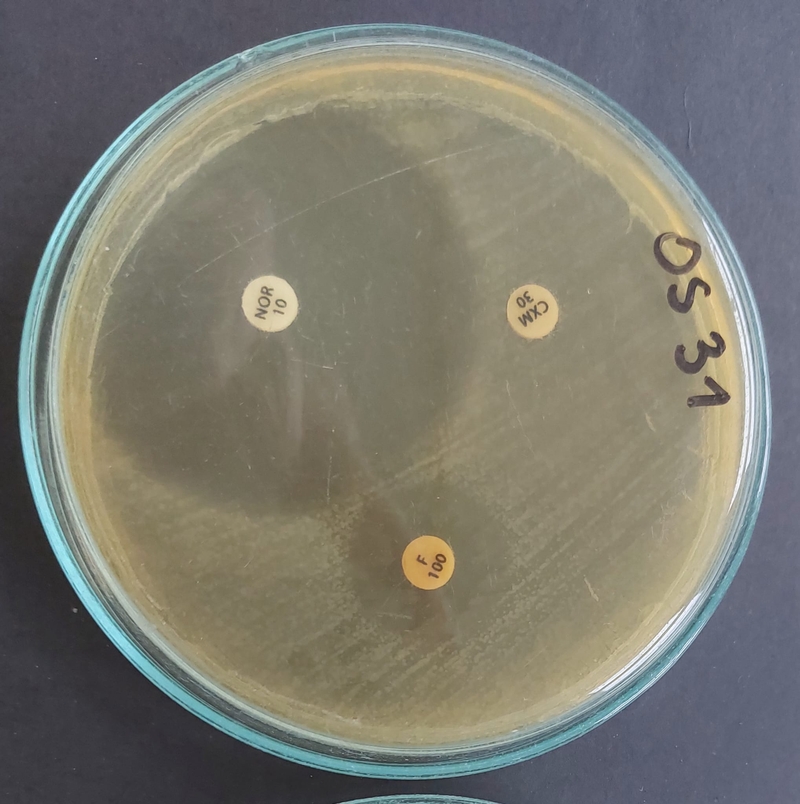

Antybiotyki to produkty naturalne, pochodzące od drobnoustrojów, produkują je niektóre bakterie i niektóre grzyby. Mają za zadanie działać hamująco lub bójczo na bakterie chorobotwórcze. – My oczywiście możemy te substancje częściowo modyfikować, a wiele z nich potrafimy już wytwarzać sztucznie, ale trzeba pamiętać, że pochodzą one od organizmów – podkreśla dr Agnieszka Zabłotni. – Samo zjawisko lekooporności, jest, więc zjawiskiem naturalnym. Przerażająca jest jego skala, z jaką mamy obecnie do czynienia. Jest coraz więcej szczepów bakteryjnych, które nie są wrażliwe na żaden znany antybiotyk, zakażenie taką bakterią często oznacza dla pacjenta śmierć.
Szacuje się, że rocznie z powodu lekooporności umiera około 700 tysięcy osób!– A trzeba pamiętać, że te dane to może być wierzchołek góry lodowej – mówi dr Zabłotni. – Nie wszystkie kraje prowadzą monitoring zgonów z powodu lekooporności, co więcej, jest też tak, że w karty zgonów nie zawsze wpisuje się lekooporność, jako przyczynę śmierci, raczej trafia tam nazwa choroby, z którą pacjent zmagał się pierwotnie. Te zgony nie są, więc ujmowane w statystykach związanych z monitorowaniem lekooporności.
Już odkrywca antybiotyków Alexander Fleming pod koniec lat 20. XX w. sygnalizował, że nadużywanie antybiotyków może być problemem, że pojawią się szczepy bakterii, które nie będą reagować na leki. – Niestety nie bardzo chciano go wówczas słuchać, zarzucano mu nawet niechęć korzystania z dobrodziejstwa antybiotyków – mówi dr Zabłotni. – Można jednak tłumaczyć, że na początku XX wieku nadużywanie antybiotyków wynikało z niewiedzy jak one działają. Sto lat później, ten argument już się nie broni.
Tym bardziej, że antybiotyki nadal są nadużywane w leczeniu ludzi, ale są również wykorzystywane w rolnictwie i hodowli. – Wiadomo, że jeśli zwierzęta chorują, należy je leczyć, problem w tym, że antybiotyki zaczęto profilaktycznie dodawać do paszy a trzeba pamiętać, że antybiotyki mogą trafiać w ten sposób nie tylko do spożywanego przez nas mięsa, ale także z odchodami do gleby, a stąd do wody – mówi dr Zabłotni. - W tej chwili w UE istnieją już regulacje, które mają zapobiegać profilaktycznemu stosowaniu antybiotyków, ale powszechnie wiadomo, że te przepisy są obchodzone. Jedno, co udało się osiągnąć, to zakaz podawania zwierzętom tych samych substancji, którymi leczeni są ludzie. Antybiotyki wykorzystywane są także w rolnictwie do zwalczania bakterii atakujących rośliny i w hodowli zwierząt wodnych. – Proszę sobie wyobrazić ogromne klatki, strefy hodowlane, w otwartych akwenach jak morza czy oceany, w których hoduje się ryby – mówi naukowczyni. – Podawane tam z paszą antybiotyki trafiają prosto do wody, nie napotykają żadnej bariery. Nic więc dziwnego, że antybiotyki są wykrywane w próbach środowiskowych nawet na obszarach słabo zaludnionych i mało rolniczych.
Antybiotykooporność to problem cywilizacyjny. Problem, który dotyka całego świata, nie tylko, jak mogłoby się wydawać, krajów wysokorozwiniętych. – Te kraje od jakiegoś czasu zdają się dostrzegać zagrożenie i wprowadzają kontrole zużycia antybiotyków – mówi dr Zabłotni. – Trzeba jednak pamiętać, że w bardzo wielu krajach antybiotyki nadal są sprzedawane bez recepty, a co za tym idzie bardzo dostępne, bardzo powszechnie stosowane, nie zawsze wtedy, kiedy jest to faktycznie potrzebne. Także w krajach cywilizowanych w społeczeństwie istnieje przekonanie, że „prawdziwe leczenie” to antybiotykoterapia. Myślą tak liczni pacjenci, próbujący nierzadko wymuszać recepty na lekarzach, ale zdarza się niestety, że lekarze wypisują je na wyrost.
Obraz przedstawia różny stopień wrażliwości bakterii na trzy antybiotyki.
– Problem polega na tym, że wielu ludzi nie wie jak działają antybiotyki, kiedy należy je przyjmować, jak to robić skutecznie, a kiedy nie wolno tego robić – mówi dr Zabłotni. – Brakuje edukacji w tym kierunku. Mało, kto rozumie, że preparaty antybiotykowe mają określony mechanizm działania i musi być utrzymany określony reżim, nie tylko żeby antybiotyki działały, ale by nie prowadziły do lekooporności. – Te substancje muszą osiągnąć w organizmie określone stężenie, bardzo ważne jest, więc przyjmowanie leków w określonych godzinach i przyjmowanie ich do końca opakowania, nawet, jeśli objawy choroby ustały – wyjaśnia dr Zabłotni. – Jeśli nie dotrzymamy tego reżimu, może się zdarzyć, że w organizmie przetrwają bakterie, które później będą oporne na ten antybiotyk. Ale to nie wszystko. Niskie dawki antybiotyków utrzymujące się w organizmie przez dłuższy czas mogą wpływać na poziom transkrypcji genów bakteryjnych. Mogą tym samym nasilać wytwarzanie np. czynników wirulencji, czyli czynników zjadliwości bakterii. – Słowem, bakteria będzie się stawać bardziej zjadliwa i skuteczniejsza w procesie wywoływania infekcji, a jednocześnie, może stać się oporna na inne antybiotyki – wyjaśnia badaczka. - Niskie dawki antybiotyków mogą też powodować zmiany w genomie – wywoływać mutacje, przez co bakteria wrażliwa na jakiś antybiotyk, pod wpływem niewłaściwej dawki stanie się niewrażliwa. Dlatego musimy chronić antybiotyki.
Konieczne jest wprowadzenie zmian systemowych, czyli ścisłych kontroli wykorzystywana antybiotyków w rolnictwie i hodowli. – Konieczna jest przede wszystkim edukacja, podniesienie świadomości społecznej – podkreśla dr Zabłotni. – Musimy uczyć pacjentów i społeczeństwo, tego jak działają antybiotyki i jak dochodzi do lekooporności. Tylko w ten sposób uda nam się ochronić antybiotyki po to, by mogły nadal chronić nas przed chorobotwórczymi bakterii.
